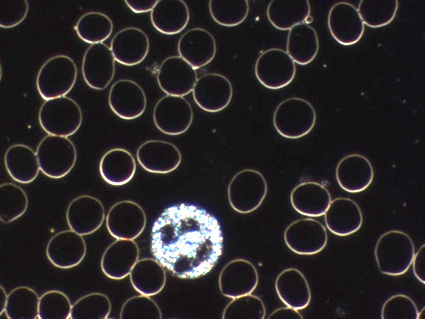

|
 |
 |
 |
 |
 |
|
|
 |
 |
 |
 |
 |
 |
|
Herzlich Willkommen
auf der Webseite von Ihrer Heilpraktikerin Marion Vigil in Dortmund Lichtendorf.
Es ist mir ein Herzensanliegen allen Interessierten die ganzheitliche Naturheilkunde n her zu bringen. Die pers nliche Begegnung und das Gespr ch mit Ihnen sind mir besonders wichtig. Ich freue mich ber Ihren Anruf und werde mir gerne Zeit f r Sie nehmen. Lassen Sie sich beraten.
Termine: nach telefonischer Vereinbarung unter 02304 331047
Falls Sie mich nicht pers nlich erreichen, hinterlassen Sie eine Nachricht und ich melde mich baldm glichst zur ck. Sie k nnen mir auch gerne Anfragen per email zusenden, die ich z gig beantworten werde. info@heilpraktikerin-vigil.de
Ich m chte Ihnen kurz einige meine Behandlungsformen vorstellen, von traditionellen Methoden wie Dunkelfeldblutuntersuchung, Akupunktur bis zur modernen Informations- und Quantenmedizin.
|
|
 |
 |
 |
 |
 |
 |
 |
 |
 |
|
Dunkelfeldmikroskopie / Vitalblutanalyse
Haben Sie ihr vitales Blut schon einmal live auf einem Bildschirm angesehen, mit all seinen Bestandteilen? Dazu wird ein frisch entnommener Bluttropfen aus der Fingerbeere auf ein spezielles Dunkelfeld Mikroskop gelegt und bis zu 1000 fach vergr ert. Mittels einer Viodeo bertragung ist es so f r den Patienten anzusehen. Nach der Blutentnahme wird die Probe in regelm igen Abst nden bis zu mehreren Tagen untersucht und dokumentiert.
Dieses schon seit ber 250 Jahren bekannte Verfahren nach Prof. Dr. G nther Enderlein hat seit vielen Jahren meine Leidenschaft f r die Dunkelfeldmikroskopie erweckt und ist in meiner Praxis eine wichtige Untersuchung. Sie gibt auch f r den Patienten Aufschluss ber das innere Milieu, bis hin zu R ckschl ssen auf den Zustand der Organe. Die Untersuchung bezieht sich sowohl auf die Quantit t als auch auf die Qualit t der Blutzellen und des Plasmas. Prof. Enderlein pr gte den Begriff des Pleomorphismus, derzufolge sich Zellen, Bakterien, Viren ineinander umwandeln und in unterschiedlichen Erscheinungsformen auftreten k nnen. Da jedes dieser Kleinstlebewesen einen Stoffwechsel hat, kann dies dem Menschen schaden.
Das entsprechende Therapieverfahren wurde von der Firma Sanum entwickelt, dazu geh ren unter anderem Entgiftung, Ents uerung, Ausleitung und die Wiederherstellung einer gesunden Darmflora.
Hier ein kleiner Ausschnitt aus einem Tropfen Blut, 1000-fach vergr ert:
Und dies ist ein anderer Tropfen, 1 Tag nach Blutentnahme:

|
|
 |
 |
 |
 |
 |
 |
 |
 |
 |
|
NES Health Scan Quantenbiologische Messung

Mit dieser modernen Messung des K rperfeldes (HBF=Human Body Field) werden innerhalb von weniger als 1 Minute einige hunderte von Messwerten ermittelt. So wird der Zustand eines jeden Patienten ohne Nebenwirkungen sehr effektiv erfasst und dargestellt. Dieses neue Verst ndnis bringt gro e Chancen f r neue diagnostische und therapeutische Ans tze. Die holistische Erfassung des Menschen von der Bewusstseinsebene bis zu organischen Manifestationen ist der brillianten Forschung von Peter Fraser und Harry Massey zu verdanken, inklusive der dazugeh rigen Therapieform mit Infoceuticals. Diese kolloidalen L sungen von Mineralien beinhalten holografische positive Informationen, wie der K rper eigentlich im gesunden Zustand sein sollte.
Wenn Sie mehr erfahren m chten schauen Sie auf die Seite www.neshealth.de. |
|
 |
 |
 |
 |
 |
 |
 |
 |
 |
|
Immunmodulationstherpie nach Spenglersan
Dr. med. Carl Spengler entwickelte eine spezielle Therapie zur St rkung der K rperabwehr. Die Spenglersan Kolloide (hochverd nnte Wirkstoffe) sind hom opathische aufgearbeitete Arzneimittel, die Antigene und Antitoxine in einer D9 Potenzierung enthalten. Mit einem einfachen Bluttest k nnen die jeweiligen Spenglersan Kolloide in der Praxis ermittelt werden. Die Aufnahme der Spenglersan-Kolloide erfolgt dabei in der Regel ber die Haut.
|
|
 |
 |
 |
 |
 |
 |
 |
 |
 |
|
Außerdem biete ich folgende Therapiearten an:
• Laboranschluss: u.a. Blut-, Stuhl-, Speichelanalysen
• Ursachenforschung/chronische Infektionen nach Rolf Jansen-Rosseck
• Heilenergetische Behandlungen nach Kahi Healing
• BioPhysio X-PowerLight
• Injektions- und Infusionstherapie
• Blutegeltherapie
• Akupunktur
• Schr pftherapie / Pneumatron Tiefengewebsmassage
• Chiropraktik
|
|
 |
 |
 |
 |
 |
 |
 |
 |
 |
 |
Kontakt
Heilpraktikerin
Marion Vigil
Ostberger Str. 3
44289 Dortmund
Telefon: 02304 331047
E-Mail: info@heilpraktikerin-vigil.de
Mobil: 0163 750 27 29
Termine: nach telefonischer Vereinbarung
|
|
|
|
|
 |
 |
 |
 |
 |
 |
 |
 |
 |
|
Impressum
Heilpraktikerin
Marion Vigil
Ostberger Str. 3
44289 Dortmund
Telefon: 02304 331047
E-Mail: info@heilpraktikerin-vigil.de
Mobil: 0163 750 27 29
Steuernummer: 31552562584 beim Finanzamt Dortmund
USt.-IdNr.: Heilkundliche T tigkeit befreit von der Umsatzsteuer gem 4 Nr.14 UStG
Gesetzliche Berufsbezeichnung: Heilpraktikerin
Aufsichtsbeh rde: Gesundheitsamt Dortmund
Die Erlaubnis zur Aus bung der Heilkunde, ohne als Arzt bestallt zu sein, wurde am
28.11.1997 von der Stadt Dortmund erteilt, nach der bestandenen berpr fung beim
Gesundheitsamt der Stadt Dortmund.
Haftung f r Links
Trotz sorgf ltiger inhaltlicher Kontrolle bernehme ich keine Haftung f r die Inhalte externer Links. F r den Inhalt der verlinkten Seiten sind ausschlie lich deren Betreiber verantwortlich.
Haftungsausschluss
Die Inhalte dieser Website wurden sorgf ltig gepr ft und nach bestem Wissen erstellt. Dennoch wird f r die hier dargebotenen Informationen kein Anspruch auf Vollst ndigkeit, Aktualit t, Qualit t und Richtigkeit erhoben. Es wird keine Verantwortung f r Sch den bernommen, die durch das Vertrauen auf die Inhalte dieser Website oder deren Gebrauch entstehen. Irrt mer und nderungen sind vorbehalten. Verl sst sich ein Anwender auf diese Informationen, so geschieht dies auf eigenes Risiko. Die Kommunikation ber das Kontaktformular oder per E-Mail erfolgt in der Regel unverschl sselt und kann unter Umst nden von unberechtigten Dritten (Hacker) eingesehen werden. Dies nimmt der Anwender in Kauf und ber cksichtigt es bei der Angabe vertraulicher Informationen. Ich bernehme keinerlei Verantwortung oder Haftung f r Sch den jeder Form als Folge der Verwendung dieser Seiten. Ebenfalls erfolgt das Herunterladen von Daten jeder Art auf eigene Gefahr.
Datenschutz
Personenbezogene Daten werden nur mit Ihrem Wissen und Ihrer Einwilligung erhoben und niemals ohne Ihre Einwilligung an Dritte weitergegeben.
Besonderer Hinweis zum HWG (Heilmittelwerbegesetz)
Aus rechtlichen Gr nden weise ich besonders darauf hin, das bei keiner der aufgef hrten Therapien der Eindruck erweckt wird , das ein Heilungsversprechen meinerseits zugrunde liegt, bzw. Linderung oder Verbesserung einer Erkrankung garantiert oder versprochen wird.
|
|
 |
 |
 |
 |
Werbung und Webdesign in Witten: kd-sign.de |
 |